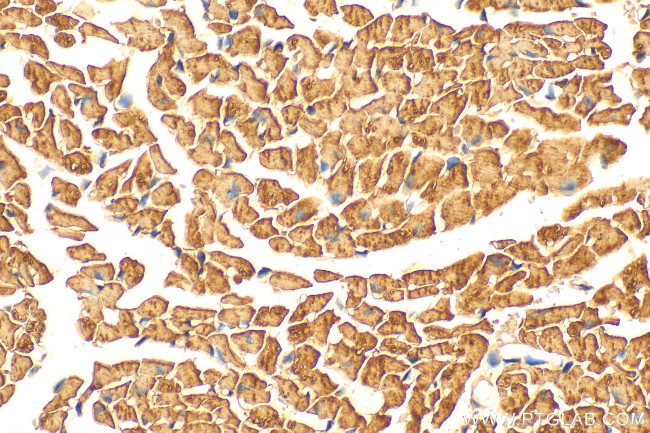
NDUFA2 Antibody in Immunohistochemistry (Paraffin) (IHC (P))

Search
Proteintech
NDUFA2 Polyclonal Antibody
{{$productOrderCtrl.translations['antibody.pdp.commerceCard.promotion.promotions']}}
{{$productOrderCtrl.translations['antibody.pdp.commerceCard.promotion.viewpromo']}}
{{$productOrderCtrl.translations['antibody.pdp.commerceCard.promotion.promocode']}}: {{promo.promoCode}} {{promo.promoTitle}} {{promo.promoDescription}}. {{$productOrderCtrl.translations['antibody.pdp.commerceCard.promotion.learnmore']}}
产品信息
15889-1-AP
种属反应
宿主/亚型
分类
类型
抗原
偶联物
形式
浓度
规格
纯化类型
保存液
内含物
保存条件
运输条件
产品详细信息
Immunogen sequence: MAAAAASRGV GAKLGLREIR IHLCQRSPGS QGVRDFIEKR YVELKKANPD LPILIRECSD VQPKLWARYA FGQETNVPLN NFSADQVTRA LENVLSGKA
靶标信息
The NDUFA2 gene encodes one of the accessory subunits of complex I, the first and largest complex of the mitochondrial respiratory chain.
仅用于科研。不用于诊断过程。未经明确授权不得转售。
篇参考文献 (0)
生物信息学
蛋白别名: CCDC76; CD14; CI-B8; complex I B8 subunit; Complex I-B8; NADH dehydrogenase (ubiquinone) 1 alpha subcomplex, 2, 8kDa; NADH dehydrogenase [ubiquinone] 1 alpha subcomplex subunit 2; NADH-ubiquinone oxidoreductase B8 subunit; NADH-ubiquinone oxidoreductase subunit CI-B8
基因别名: AV000592; B8; C1-B8; CD14; CI-B8; CIB8; MC1DN13; NDUFA2
UniProt ID: (Human) O43678, (Mouse) Q9CQ75
Entrez Gene ID: (Human) 4695, (Rat) 291660, (Mouse) 17991